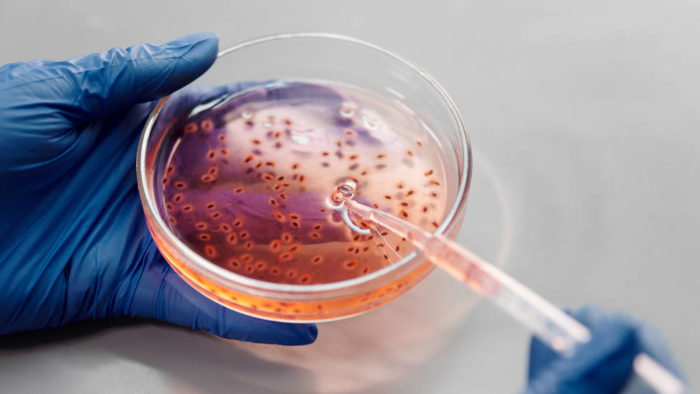

Detectan en China un nuevo virus de origen animal: ya hay 35 contagiados con el Langya
Un estudio científico reveló la detección en dos provincias chinas de 35 contagios en humanos de un nuevo virus de origen animal del tipo Henipavirus, informaron hoy medios estatales.
Un estudio científico reveló la detección en dos provincias chinas de 35 contagios en humanos de un nuevo virus de origen animal del tipo Henipavirus, informaron hoy medios estatales.
Los casos, ninguno de ellos grave, se hallaron en Shandong (este) y Henan (centro), según el diario oficialista Global Times, que cita un artículo publicado por científicos chinos y de Singapur en el New England Journal of Medicine, una de las publicaciones médicas más prestigiosas del mundo.
El virus, para el que no existen por ahora vacunas o tratamientos, fue detectado mediante muestras tomadas de la garganta de pacientes que habían tenido contacto reciente con animales y se asocia con síntomas como fiebre, cansancio, tos, pérdida del apetito, dolores de cabeza y musculares y náuseas.
De acuerdo al diario, investigaciones posteriores revelaron que 26 de los 35 pacientes portadores de este Henipavirus desarrollaron esos síntomas clínicos, a los que se suman irritabilidad y vómitos.
Según el portal de noticias estatal The Paper el Henipavirus es una de las principales causas emergentes del salto de enfermedades animales a humanos (proceso denominado zoonosis) en la región de Asia-Pacífico.
Dicho medio indica que uno de los vectores de transmisión del virus son los murciélagos de la fruta, considerados huéspedes naturales de dos de los Henipavirus conocidos: el virus Hendra (HeV) y el Nipah (NiV).
El coronavirus no será el único que provoque una pandemia
La Organización Mundial de la Salud (OMS) señala que el virus Hendra provoca en humanos infecciones que van desde asintomáticas a infecciones respiratorias agudas y encefalitis graves, con una tasa estimada de fatalidad de entre el 40 y el 75 % que “puede variar en función de las capacidades locales de investigación epidemiológica y manejo clínico”.
Por el momento, afirma el Global Times, no se ha probado que exista transmisión de persona a persona, aunque informes previos señalan que este tipo de contagio tampoco es descartable.
“El coronavirus no será la última enfermedad contagiosa que provoque una pandemia, ya que nuevas enfermedades tendrán un impacto cada vez mayor en la vida diaria de la raza humana”, declaró el subdirector del departamento de Patologías Infecciosas del hospidal Huashan, afiliado a la Universidad de Fudan (Shanghái).












Y todos los que quieran inventar, mientras haya periodistas que lo divulguen.
YA SE ESTAN INVENTANDO OTRA MIERDA.
No se antoja raro que de toda la vida hay una pandemia mundial cada 100 años aproximadamente, y ahora se declara una pandemia cada año? Estos enfermos sedientos de dinero quieren meternos vacunas como a toro banderillas todos los años para nutrir sus bolsillos y de paso reducir la poblacion mundial, arruinar la economia provocando cierres, fallos en la cadena de suministro, hambre, miseria y ahi cuando todo este en el suelo, implantar el nuevo orden mundial autoritario sin libertades de ningun tipo.